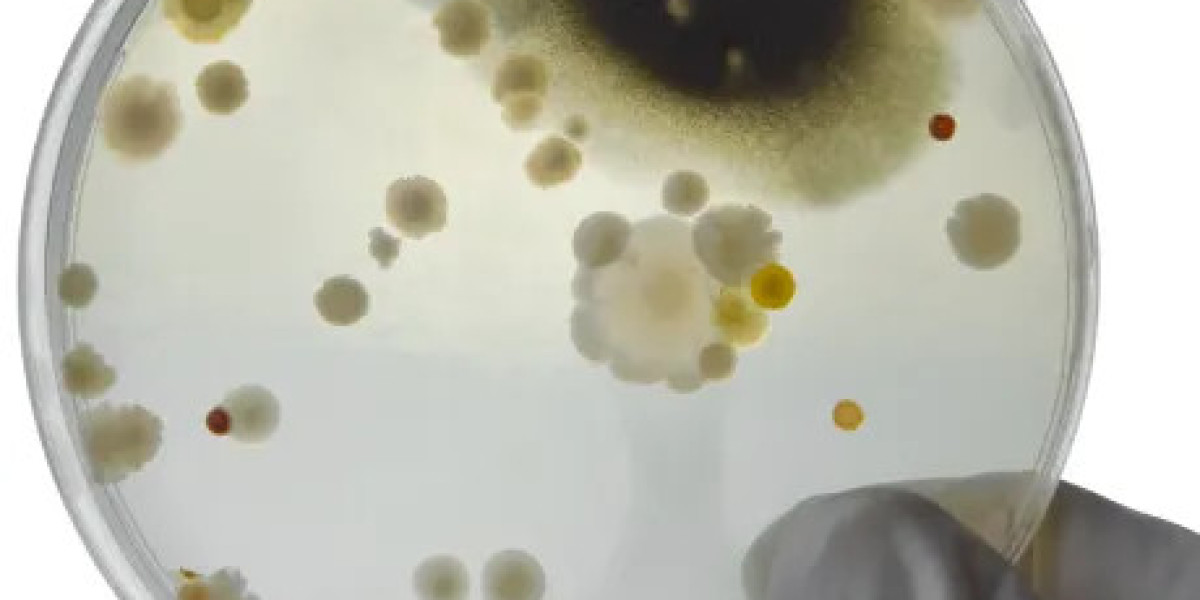

If you're new to vaping or a seasoned vaper, you know that not all e-liquids are created equal. The perfect vaping experience depends on a multitude of factors, but the key ingredient for an exceptional vape is often Nic Salt E-Liquid. And when it comes to Nic Salt, Bar Juice E-Liquid has perfected it like no other.
Imagine enjoying a smooth, satisfying hit with every puff, where the nicotine hits you just the way you need it without the harshness that often ruins the experience. If you're tired of struggling with harsh throat hits, inconsistent flavours, or nicotine that just doesn’t satisfy, it’s time to take a closer look at Bar Juice Nic Salt.
In this blog, we’re revealing Bar Juice’s #1 rule for perfect Nic Salt vaping, and why it’s a game-changer for vapers everywhere. Whether you’re switching from cigarettes, transitioning to vaping, or simply looking for a smoother experience, this is the guide you need.
Why Vaping Can Sometimes Feel Off ?
For many vapers, the journey from smoking to vaping can feel like an uphill battle. One of the biggest challenges is finding the right nicotine strength and flavour balance. Traditional e-liquids often lead to a harsh throat hit, leaving you feeling unsatisfied or uncomfortable. This is especially true for those who have recently made the switch from smoking.
But here’s the real kicker: Nic Salt, the smoother, faster-absorbing form of nicotine, was created to solve this exact issue! Yet, even among Nic Salt e-liquids, many brands still miss the mark. You’ll find flavours that don’t hit right, throat hits that are still harsh, and even overpowering nicotine strengths that can turn a pleasant experience into a chore.
So, how can you avoid all that and find the smooth, satisfying vape you’ve been looking for?
Bar Juice’s #1 Rule for Perfect Nic Salt Vaping: The Ideal Balance
Bar Juice Nic Salt is not just another e-liquid—it’s a carefully crafted experience built on the #1 rule for perfect Nic Salt vaping: Finding the perfect balance of nicotine strength, smoothness, and flavour.
Here’s how Bar Juice achieves that perfect balance:
Nicotine Salt Formula – Smooth, Fast Absorption
Unlike traditional e-liquids that use freebase nicotine, Nic Salt uses nicotine that’s combined with an acid, making it smoother on the throat and absorbed faster. This means you’ll feel the effects of the nicotine almost instantly, without the harsh, throat-clenching feeling often experienced with regular nicotine juices.Nicotine Strength Variations – Tailored to You
Bar Juice Nic Salt offers multiple nicotine strengths (10mg, 20mg), allowing you to choose the strength that works best for your personal preference. This flexibility makes Bar Juice flavours a perfect choice whether you're transitioning from smoking or just want a tailored vaping experience.Flavour Mastery – Smooth Yet Bold
While nicotine satisfaction is key, flavour plays a huge role in your vaping experience. Bar Juice offers a wide range of flavours—from classic fruit blends to exotic creations—each formulated to provide a smooth and consistent taste with every puff. Unlike other Nic Salt brands, Bar Juice ensures that the flavours don’t overpower the nicotine hit, but complement it.
Step-by-Step Guide to Perfect Vaping with Bar Juice Nic Salt
Let’s walk you through the steps to perfect your vape experience with Bar Juice Nic Salt.
1. Choose the Right Nicotine Strength
Picking the right nicotine strength is crucial to ensure a smooth and enjoyable experience. If you’re a former smoker or you’ve been vaping for a while, you may want to start with 20mg nicotine for a stronger hit. If you’re just starting or prefer a lighter experience, 10mg nicotine should be your go-to. Experiment with strengths until you find the one that provides the most satisfaction without feeling overwhelmed.
2. Select the Right Device
Using the right device for Nic Salt is critical. Low-wattage pod systems work best for Nic Salt e-liquids, as they deliver a smoother hit and allow the flavours to shine. Avoid using high-powered mods, as they can burn the Nic Salt and alter the experience.
3. Take Slow, Steady Puffs
Nic Salt is designed to deliver a satisfying hit without harshness. Inhale slowly and steadily to let the nicotine fully absorb and experience the flavours at their best. Taking fast, heavy hits can cause the e-liquid to burn, which defeats the purpose of using Nic Salt.
4. Experiment with Flavours
Don’t settle for just one flavour—Bar Juice has a wide range of flavours to suit every taste. Whether you’re a fan of fruity flavours, menthol, or exotic blends, Bar Juice has something for everyone. Try a few different flavours and find your favourite, or mix and match for your own unique vaping experience.
When a leading vape store chain switched to Bar Juice Nic Salt, they saw a 40% increase in customer satisfaction and a 25% boost in repeat customers within just one month. This was due to the smooth, flavorful, and balanced vaping experience Bar Juice delivers.
Why You Should Make the Switch to Bar Juice Nic Salt
Bar Juice Nic Salt isn't just another e-liquid—it's a carefully crafted vaping experience that combines the best of smoothness, nicotine satisfaction, and flavour richness. Whether you’re a newbie to vaping or an experienced vaper, Bar Juice guarantees a premium, consistent experience every time.
Elevate Your Vaping Experience Today
Perfecting your vape experience isn’t just about finding any juice—it’s about finding one that provides the smoothest hit, the best flavours, and the right nicotine strength. Bar Juice Nic Salt brings all of that and more.
Are you ready to take your vaping experience to the next level? Shop Bar Juice Nic Salt now and discover why it’s the top choice for vapers worldwide.